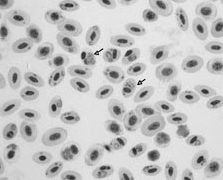

胞子虫類
胞子虫類 鶏マラリア(症状・予防) ~ 死亡率は日齢の若いものほど高い
鶏に感染性のある、Plasmodium属原虫は、実験感染も含めれば多くの種類を数えるが、自然感染が認められる重要な種類はP.juxtanucleareとP.gallinaceumの2種類です。本邦の鶏に寄生が確認されている種類は、P.jux...
胞子虫類
胞子虫類  P
P  M
M  C
C  アヒルの病気
アヒルの病気